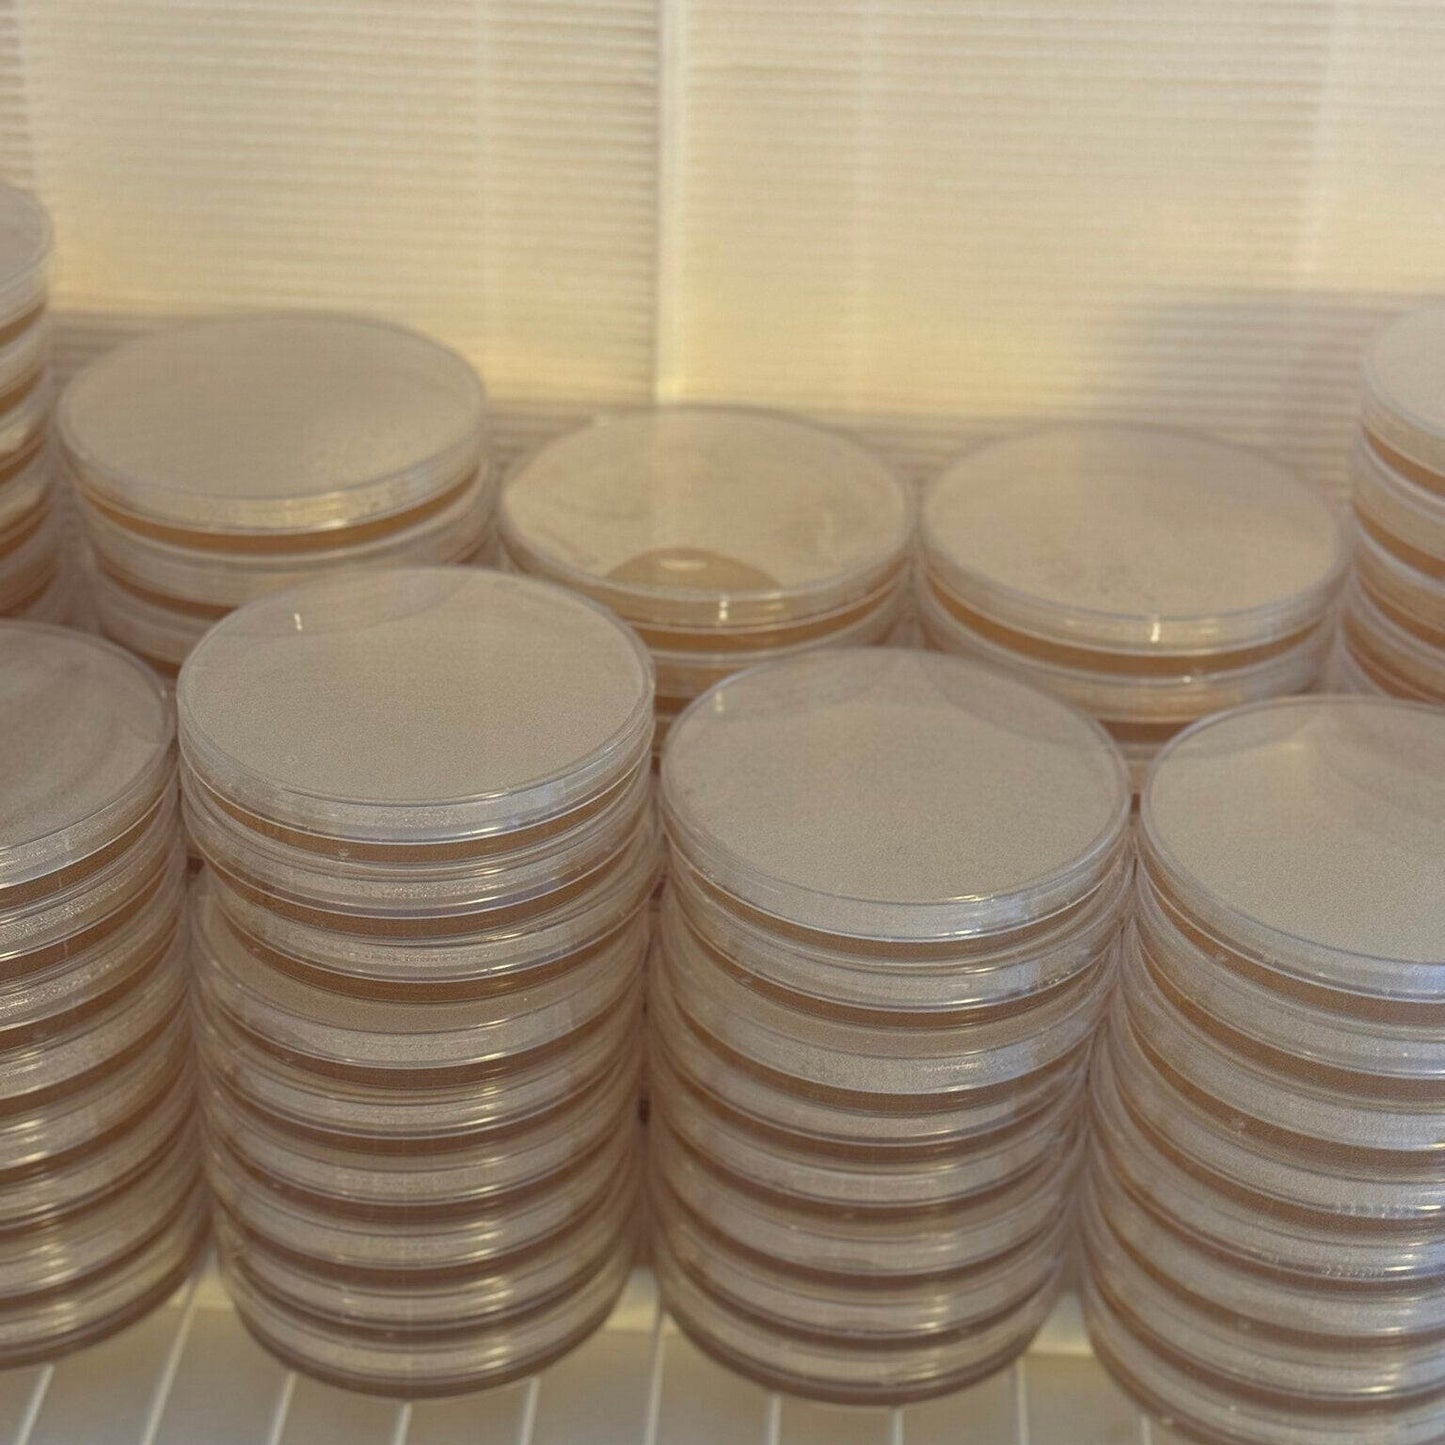
Petriskåler-ferdig-fylt-fra-soppbutikken.no

Soppbutikken
Petriskåler/Laboratorieskåler ferdig fylt
Petriskåler/Laboratorieskåler ferdig fylt
Kunne ikke laste inn hentetilgjengelighet
Petriskåler/Laboratorieskåler ferdig fylt 10 pk
Pakken for deg som ønsker ferdig preparerte laboratorieskåler.
10 stk ferdigfylte petriskåler/laboratoriedisker.
Ferdig fremstilte laboratorieskåler sterilisert og klar til bruk, om du for eksempel trenger å kvalitetssjekke din flytende kultur, dyrke frem myselium fra sporer eller prøve å klone, så er dette det perfekte valget.
Vi har valgt å tilby de mest brukte variantene av næringsmedium slik at du finner det du måtte trenge til ditt prosjekt.
Et næringsmedium er et preparat eller en løsning til å dyrke, lagre eller transportere mikroorganismer i. Næringsmediet er en blanding av stoffer som er nødvendige for at en bestemt mikroorganisme skal overleve eller vokse. Næringsmediet kan være flytende eller fast.
90mm petriskåler ferdig fylt og klar til bruk.
Brukes optimalt innen 1 mnd, bør brukes inne 2 mnd.
Vi anbefaler å bruke parafilm til forsegling av skålene.
Velg mellom MEA, MYA, PDA, vann agar, MEA med aktivt kull og MEA med pepton.
Dette er et produkt som produseres på bestilling for å sikre prima kvalitet.
Det må påregnes ca 1 uke produksjonstid.
Når du mottar denne varen så er det anbefalt å la den ligge et par dager for å se at det ikke har oppstått kontaminasjon under transport.
OBS: Kuldesensitiv, tåler ikke frost.
Share